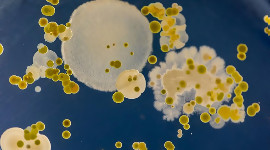

След края на сделката: Американците масово се оттеглят от TikTok

В края на миналата седмица, сделката по прехвърлянето на собствеността на TikTok US в американски ръце беше приключена. И скоро след това десетки местни потребители на приложението започнаха да го премахват от устройствата си. Както знаете, от години Вашингтон подозира ByteDance, че прави нещо нередно чрез приложението си и социалната мрежа към него TikTok. Те […]
Прочети цялата публикация

Орбан за помощта към Украйна: Американците имаха разума да се оттеглят в правилния момент
Орбан за помощта към Украйна: Американците имаха разума да се оттеглят в правилния момент  Гари Каспаров: Западът се страхува от Трета световна война, но Путин вече води Четвърта!
Гари Каспаров: Западът се страхува от Трета световна война, но Путин вече води Четвърта!  Гари Каспаров: Западът се страхува от Трета световна война, но Путин вече води Четвърта!
Гари Каспаров: Западът се страхува от Трета световна война, но Путин вече води Четвърта!  Ройтерс: Индия планира да намали митата за автомобили от ЕС до 40%
Ройтерс: Индия планира да намали митата за автомобили от ЕС до 40%  Какво се знае за евентуалното споразумение за Гренландия
Какво се знае за евентуалното споразумение за Гренландия  Русия се въоръжава здраво, но не за войната с Украйна
Русия се въоръжава здраво, но не за войната с Украйна  Сделката за запазване на TikTok в САЩ най-накрая е финализирана
Сделката за запазване на TikTok в САЩ най-накрая е финализирана  Ако Путин постигне своето, Европа ще бъде пометена от ефекта на доминото
Ако Путин постигне своето, Европа ще бъде пометена от ефекта на доминото  Тръмп преобръща световния ред
Тръмп преобръща световния ред  Унгарската петролна компания купува целия мажоритарен руски дял в Сърбия
Унгарската петролна компания купува целия мажоритарен руски дял в Сърбия  Парадокси в лечението с антибиотици и как губим битката срещу бактериите
Парадокси в лечението с антибиотици и как губим битката срещу бактериите  Съдът е призовал за разпит полицаи по делото срещу Кирил Петков
Съдът е призовал за разпит полицаи по делото срещу Кирил Петков  Удинезе триумфира над Верона като гост и се изкачи в класирането на Серия А
Удинезе триумфира над Верона като гост и се изкачи в класирането на Серия А  След края на сделката: Американците масово се оттеглят от TikTok
След края на сделката: Американците масово се оттеглят от TikTok  "Важна стъпка": Франция забранява социалните мрежи за деца под 15 години
"Важна стъпка": Франция забранява социалните мрежи за деца под 15 години  Арина Сабаленка: Тези тийнейджърки ме тестват сериозно
Арина Сабаленка: Тези тийнейджърки ме тестват сериозно  Колко близо е човечеството до края си? Часовникът на Страшния съд ще покаже днес
Колко близо е човечеството до края си? Часовникът на Страшния съд ще покаже днес  Руска атака срещу Одеса, има пострадали
Руска атака срещу Одеса, има пострадали  Одеса бе подложен на масирана руска атака. Украйна: Има сериозни разрушения
Одеса бе подложен на масирана руска атака. Украйна: Има сериозни разрушения